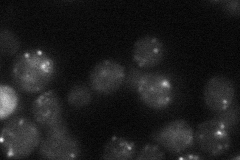
YOR284W

View description
Cytoplasmic protein of unknown function; computational analysis of large-scale protein-protein interaction data suggests a possible role in actin patch assembly
Localization:
Intensity:
Fold change:
Significance:
-
C’ GFP library in SD

punctate22.61 -
N' NOP1pr-GFP in SD

punctate64.5624 -
N' TEF2pr-mCherry in SD

punctate118.554 -
N' NATIVEpr-GFP in SD
punctate26.545 -
N' TEF2pr-VC and Cyto-VN in SD

punctate33.3315 -
C’ GFP library in SD+DTT

punctate24.481.08No -
C’ GFP library in SD+H2O2

punctate21.060.93No -
C’ GFP library in Starvation Media

punctate24.251.07No -
C’ GFP library on the background of Pup2-DaMP

punctate -
C’ GFP library on the background of CCT mutant

punctate19.40970.85818No
